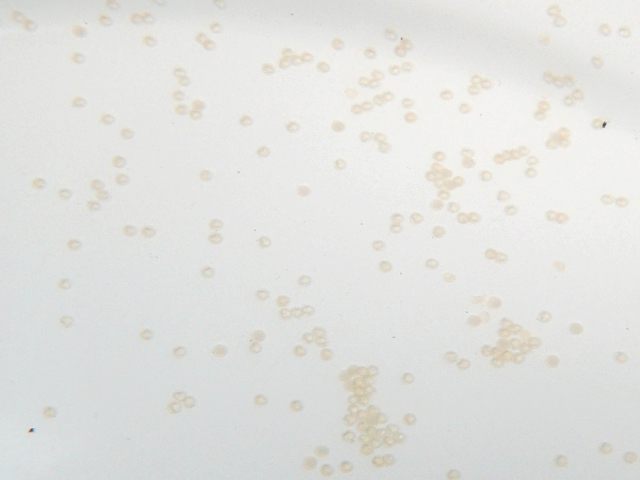

成長記録(当歳)其の壱
同腹兄弟魚の成長記録
▼ 2013年3月9日 【産卵】
・種親掛け合わせ(上がメス親、下がオス親)


▼ 2013年3月10日 【産卵から1日】
▼ 2013年3月11日 【産卵から2日】

▼ 2013年3月20日 【孵化から11日】

▼ 2013年3月27日 【孵化から18日】

▼ 2013年4月7日 【孵化から29日】


▼ 2013年4月13日 【孵化から35日】

▼ 2013年4月18日 【孵化から40日】

▼ 2013年5月7日 【孵化から59日】


▼ 2013年5月18日 【孵化から70日】

▼ 2013年6月29日 【孵化から112日】

▼ 2013年7月17日 【孵化から130日】

▼ 2013年8月5日 【孵化から149日】
・7月17日の記録の魚です。

▼ 2013年8月30日 【孵化から174日】
・8月5日の記録の魚です。

▼ 2013年10月14日 【孵化から219日】(最終記録)
・8月30日の記録の魚です。

